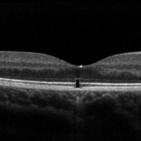

-
 Macroaneurysm
Macroaneurysm
Feb 6 2018 by Bastián Schmidt Arias
Fundus photograph of an 90-year-old woman with a retinal arterial macroaneurysm.
Photographer: Bastian Schmidt
Imaging device: TRC-50DX - Topcon
Condition/keywords: fundus photograph, macroaneurysm
-
Laser Pointer Maculopathy
Laser Pointer Maculopathy
Apr 28 2019 by Bastián Schmidt Arias
Optical coherence tomography of a 13-year-old adolescent with a laser pointer maculopathy, 20/20 visual acuity with paracentral scotoma.
Photographer: Bastian Schmidt
Imaging device: Topcon 3D OCT-2000
Condition/keywords: laser pointer maculopathy, maculopathy, optical coherence tomography (OCT)
-
 Coloboma of Optic Disc
Coloboma of Optic Disc
Apr 28 2019 by Bastián Schmidt Arias
Fundus photograph of an 63-year-old woman with retinal coloboma.
Photographer: Bastian Schmidt
Condition/keywords: coloboma of optic disc

A project from the American Society of Retina Specialists